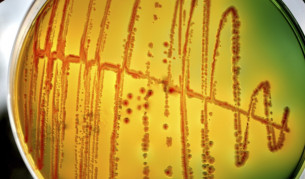
Получиха гориво с помощта на бактерии Е. коли

Наука и техника

Що е то "баналност на злото"?
09.09.2014
Може ли всеки индивид да приспи съзнанието си за добро и лошо, ако сляпо се подчинява на авторитарна личност

Детектор ще "вижда" под повърхността на тялото
09.09.2014
Учени са създали прототип, който е в състояние да проникне в широк спектър от дължини на вълните - в това число и в изключително трудните...

НАСА ще събира "уникални сведения" за Земята
09.09.2014
По думите на ръководителя на научната програма на МКС в космическия център "Джонсън" в град Хюстън "нова ера в наблюдаването на Земята ще...

Петима учени си поделят престижните награди "Ласкер"
09.09.2014
Призът за специален принос към медицинската наука се присъжда на Мери-Клер Кинг, която през 1990 г. идентифицира участък в човешката ДНК...

Карта на океаните посочва виновниците за боклука
08.09.2014
Боклуците по морската повърхност се носят не както се очаква, защото границите на океаните са различни от възприетите. Така, макар и...

Динозаврите се оказват по-стари
08.09.2014
Изследвания показват, че същества с размерите на кучета и котки, които обитавали земята преди 245 млн. години най-вероятно са били...

Умен бастун ще помага на хора с проблеми със зрението
08.09.2014
Целта е на тези хора да се гарантират по-автономно движение и по-голяма сигурност в градска среда

Акулите убиват 9 пъти повече мъже, отколкото жени
06.09.2014
Според последно проучване при непредизвиканите нападения на тези морски хищници с фатален изход в 84 на сто от случаите загиват...

Разкриха генетичните тайни на кафето
05.09.2014
Това, което кара хората да обичат ободрителната напитка - кофеинът, е генетична приумица, различна от кофеина в шоколада или чая

Астероид ще премине край Земята в неделя
05.09.2014
Опасност за сблъсък няма

Четвърт от езиците в света са на ръба на изчезване
05.09.2014
Изследване показва, че са на път да изчезнат езици, които се говорят в северозападните краища на САЩ и Канада, в Австралия, както и в...

Аржентински динозавър се е извисявал над Т. рекс
04.09.2014
Учени откриха в Южна Патагония необичайно пълен и добре запазен фосил на динозавъра Dreadnoughtus schrani, който е тежал 65 тона, а...

Млечният път обитава "неизмерим рай"
04.09.2014
Учени откриха, че галактиката ни обитава покрайнините на неизвестен досега масивен галактичен свръхкуп

Още 30 човека ще работят по разкопките на Перперикон
04.09.2014
Заради закъснялото начало на проучванията, археологическият екип ще продължи работа и през октомври

Бил Гейтс дари 25 млн. долара за ваксина срещу СПИН
04.09.2014
При тестове с маймуни при половината от животните ваксината е спряла предаването или е елиминирала напълно форма на вируса
Получиха гориво с помощта на бактерии Е. коли
03.09.2014







